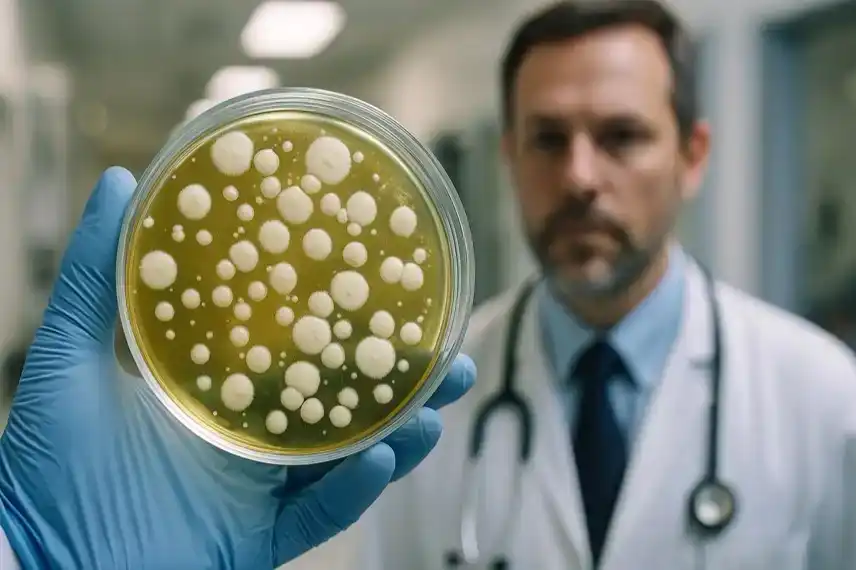
Pilzkultur in einer Petrischale

Die Berliner Charité hat einen Ausbruch des gefährlichen Hefepilzes Candidozyma auris bestätigt. Mehrere Patienten sind betroffen, die meisten tragen den Erreger bislang symptomlos, doch einige zeigen bereits Krankheitsanzeichen. Für die Allgemeinheit gilt das Risiko als gering, in Kliniken jedoch ist die Lage ernst, da immungeschwächte Patienten besonders gefährdet sind.
Ein neuer Ausbruch sorgt für Schlagzeilen
Die Charité Berlin hat nach eigenen Angaben einen Ausbruch des Pilzes Candidozyma auris gemeldet, der früher unter dem Namen Candida auris bekannt war. Nach Informationen aus der Klinik gibt es derzeit eine „niedrige zweistellige Zahl“ an Betroffenen. Dabei handelt es sich größtenteils um Fälle, in denen der Pilz den Körper besiedelt, ohne Symptome auszulösen. Allerdings sind auch Erkrankungen bestätigt worden – mindestens zwei Patienten entwickeln klinische Anzeichen einer Infektion, ein weiterer Fall wird derzeit untersucht.Der erste Nachweis erfolgte bereits im Juni, bei einem Patienten, der zuvor in einer ausländischen Einrichtung behandelt worden war. Dort hatte er sich vermutlich infiziert, bevor der Erreger in Berlin entdeckt wurde. Durch Urinproben konnte der Befund eindeutig bestätigt werden. Seither hat sich der Erreger auch innerhalb der Charité weiter ausgebreitet.
Was ist Candidozyma auris?
Was ist Candidozyma auris und wie unterscheidet er sich von anderen Pilzen? Diese Frage stellen sich aktuell viele Menschen, seitdem der Ausbruch in der Hauptstadt Schlagzeilen macht. Candidozyma auris wurde erstmals 2009 beschrieben und gilt als besonders problematisch, weil er in medizinischen Einrichtungen lange überleben und schwer zu bekämpfen ist. Während andere Hefepilze wie Candida albicans vor allem Haut- und Schleimhautinfektionen verursachen, kann C. auris tief in den Körper eindringen und lebensbedrohliche Infektionen hervorrufen.Besonders auffällig ist seine Resistenzlage: Viele Stämme sind gegen gängige Antimykotika wie Fluconazol oder Amphotericin B resistent. Lediglich moderne Echinocandine gelten noch als vergleichsweise wirksam. Zudem hält sich der Pilz auf Krankenhausoberflächen, Geräten oder Bodenbelägen über Wochen, manchmal sogar Monate, und kann so immer wieder neue Infektionen auslösen.
Symptome und Krankheitsverlauf
Welche Symptome treten bei einer Infektion mit Candidozyma auris auf? Betroffene zeigen oftmals unspezifische Beschwerden wie Fieber, Schüttelfrost, Schwächegefühl oder Atemprobleme. Bei invasiven Infektionen kann es zu schweren Blutstrominfektionen, Organversagen oder Sepsis kommen. Auch Infektionen der Harnwege, der Ohren oder offener Wunden sind dokumentiert. Problematisch ist, dass die Symptome kaum von bakteriellen Infektionen zu unterscheiden sind – und dass herkömmliche Therapien häufig nicht greifen.Übertragungswege in Krankenhäusern
Wie wird Candidozyma auris in Krankenhäusern übertragen und eingedämmt? Nach den Recherchen erfolgt die Übertragung meist durch direkten Kontakt mit infizierten oder besiedelten Personen. Auch kontaminierte Geräte, Katheter, Beatmungsschläuche oder Flächen können den Erreger weitergeben. In der Charité wurden daher sofort umfassende Maßnahmen ergriffen: Isolation betroffener Patienten, Desinfektionsroutinen mit speziell wirksamen Mitteln sowie Screening-Programme, insbesondere bei Neuaufnahmen aus ausländischen Kliniken.Diese Hygieneketten sind entscheidend, um die weitere Ausbreitung zu verhindern. Ein Ausbruch wie in Berlin zeigt, wie verwundbar auch moderne Krankenhäuser gegenüber multiresistenten Erregern sind.
Gefährdete Patientengruppen
Wer ist besonders gefährdet, sich mit Candidozyma auris zu infizieren? Als Hochrisikogruppe gelten Menschen mit geschwächtem Immunsystem, darunter Krebspatienten, Organtransplantierte oder ältere Menschen. Auch Patienten auf Intensivstationen, die invasive Eingriffe oder Geräte wie Katheter benötigen, haben ein deutlich erhöhtes Risiko. Eine längere Antibiotika- oder Antimykotika-Behandlung kann das Risiko zusätzlich erhöhen, weil dadurch die natürliche Abwehrflora geschwächt wird.Fachärzte betonen, dass für gesunde Menschen im Alltag kaum eine Gefahr besteht. Das Risiko ist primär in Kliniken oder Pflegeeinrichtungen hoch – dort, wo viele vulnerable Personen zusammenkommen.
Entwicklung der Fallzahlen in Deutschland und Europa
Wie häufig kommen Fälle von Candidozyma auris in Deutschland vor und wie ist die Meldepflicht geregelt? Zwischen 2013 und 2023 wurden in Deutschland etwa 120 Fälle dokumentiert. Während die Zahl lange stabil blieb, ist seit 2023 ein deutlicher Anstieg zu beobachten. Allein im vergangenen Jahr wurden nach Daten des Nationalen Referenzzentrums für Mykosen 77 Fälle gemeldet – etwa sechsmal mehr als in den Jahren zuvor. Besonders auffällig: Die meisten Nachweise betreffen zunächst nur Besiedlungen, aber auch invasive Infektionen häufen sich.Seit Juli 2023 besteht für Nachweise aus Blut oder sterilen Materialien eine Meldepflicht nach dem Infektionsschutzgesetz. Das bedeutet: Jeder Nachweis einer invasiven Infektion muss den Behörden gemeldet werden. Zusätzlich gilt eine Meldepflicht bei Ausbrüchen in Einrichtungen.
Europa im Vergleich
Auch europaweit ist die Entwicklung besorgniserregend. Nach Angaben der europäischen Seuchenschutzbehörde ECDC wurden zwischen 2013 und 2023 über 4.000 Fälle in EU- und EWR-Staaten registriert, mit einem starken Anstieg im Jahr 2023 auf mehr als 1.300 Fälle. Besonders betroffen sind Länder wie Spanien, Italien und Griechenland, doch auch Deutschland gehört mittlerweile zu den Staaten mit wachsender Fallzahl.| Jahr | Deutschland (gemeldete Fälle) | EU/EWR gesamt |
|---|---|---|
| 2013–2022 | ca. 43 | ca. 2.666 |
| 2023 | 77 | 1.346 |
| Gesamt | 120+ | 4.012 |
Wie gefährlich ist der Ausbruch für die Allgemeinheit?
Wie gefährlich ist ein Ausbruch wie an der Charité für die Allgemeinheit? Laut Experten ist das Risiko für gesunde Menschen sehr gering. Der Pilz stellt vor allem für Patienten in Kliniken eine Bedrohung dar, insbesondere wenn das Immunsystem geschwächt ist. „Es besteht keine akute Gefahr für die allgemeine Bevölkerung“, heißt es aus Fachkreisen, „aber für betroffene Einrichtungen ist die Lage ernst.“Problematisch ist vor allem die Möglichkeit, dass sich der Pilz unbemerkt ausbreitet. Viele Patienten sind besiedelt, ohne Symptome zu zeigen. Dadurch kann der Erreger weitergegeben werden, ohne dass eine Infektion sofort auffällt. Deshalb sind Screening-Programme und strikte Isolationsmaßnahmen unverzichtbar.
Behandlungsmöglichkeiten und Grenzen der Medizin
Welche Behandlungsmöglichkeiten gibt es gegen Candidozyma auris und wie wirksam sind sie? Ärzte setzen derzeit vor allem Echinocandine ein. Diese Antimykotika gelten als vergleichsweise effektiv, doch auch hier wurden bereits resistente Stämme beschrieben. In einigen Ländern zeigen sich Resistenzen gegen gleich mehrere Wirkstoffklassen. Dies macht den Pilz zu einem der am schwersten behandelbaren Erreger, weshalb die Weltgesundheitsorganisation ihn in die höchste Prioritätsstufe für gefährliche Pilzpathogene eingeordnet hat.Eine erfolgreiche Behandlung hängt vom Resistenzprofil des Pilzes ab, das in Laboren ermittelt wird. Neben Medikamenten müssen Infektionsquellen beseitigt und Hygienemaßnahmen strikt eingehalten werden, damit eine Therapie Aussicht auf Erfolg hat.
Forschung und Wissenslücken
Forscher betonen, dass es noch viele offene Fragen gibt. So ist nicht abschließend geklärt, warum der Pilz zeitgleich in verschiedenen Weltregionen aufgetreten ist. Auch die Umweltpersistenz – also die Fähigkeit, wochen- oder monatelang auf Flächen zu überleben – stellt Wissenschaftler vor Herausforderungen. Zudem wird diskutiert, ob der Einsatz von Fungiziden in der Landwirtschaft die Entwicklung resistenter Stämme beschleunigt haben könnte.Stimmen aus der Praxis
„Wir beobachten die Situation mit hoher Aufmerksamkeit“, heißt es aus der Charité. Auch andere Kliniken melden eine erhöhte Wachsamkeit. In Bayern wurde 2023 ein längerer Ausbruch dokumentiert, der nur durch schnelle Kooperation von Klinik, Gesundheitsamt und Landesamt für Gesundheit eingedämmt werden konnte. Dort zeigte sich, dass eine frühzeitige Reaktion entscheidend ist, um eine unkontrollierte Ausbreitung zu verhindern.Der Ausbruch von Candidozyma auris an der Berliner Charité zeigt, wie ernst die Bedrohung durch neuartige und resistente Erreger in modernen Gesundheitssystemen ist. Für gesunde Menschen besteht keine akute Gefahr, doch in Krankenhäusern mit vulnerablen Patienten stellt der Pilz eine erhebliche Herausforderung dar. Mit strengen Hygienemaßnahmen, gezielter Forschung und einer klaren Meldepflicht lassen sich Ausbreitungen eindämmen. Der aktuelle Vorfall macht jedoch deutlich, dass Deutschland und Europa besser vorbereitet sein müssen, um künftigen Ausbrüchen rechtzeitig und wirksam begegnen zu können.